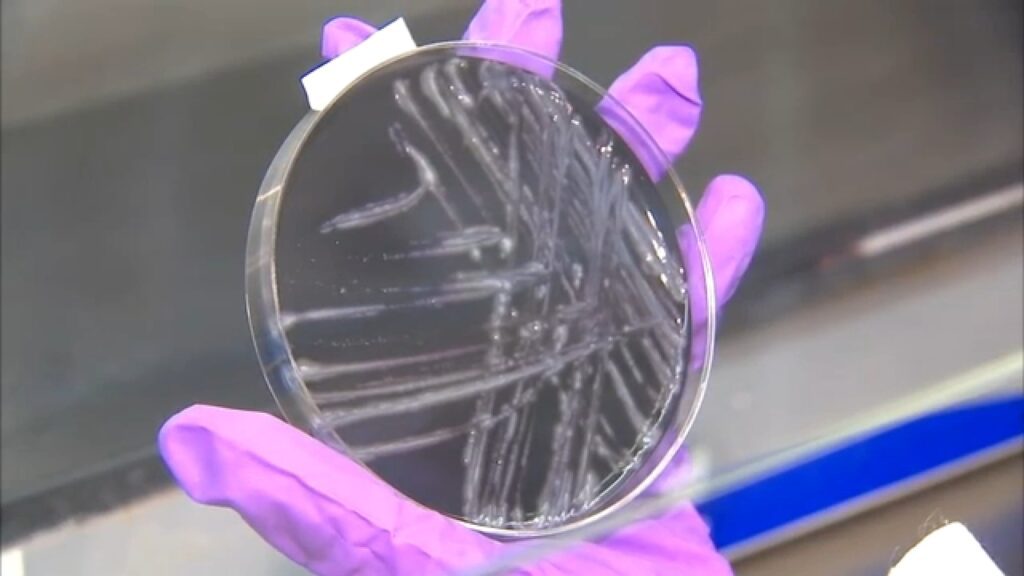

Surto de Doença dos Legionários em Harlem Central, NYC
Um surto de Doença dos Legionários foi registrado em Central Harlem, Nova York, com a confirmação de cinco casos. As autoridades de saúde estão investigando a origem desse surto, que representa um risco significativo à saúde pública na região.
Investigação em Andamento
A equipe de saúde pública está realizando uma investigação minuciosa para identificar a fonte da infecção. A Doença dos Legionários é causada pela bactéria Legionella, que pode ser encontrada em água contaminada, especialmente em sistemas de resfriamento, chuveiros e fontes decorativas.
Informação sobre a Doença
Os sintomas da Doença dos Legionários incluem febre, calafrios, tosse e dificuldades respiratórias, que podem se agravar em casos mais severos. É importante que pessoas que apresentem esses sinais procurem atendimento médico imediatamente. O tratamento precoce é essencial para a recuperação.
Alertas à Comunidade
As autoridades de saúde de Nova York recomendam que a população permaneça alerta e busque informações atualizadas sobre possíveis áreas de risco. Os meios de comunicação locais estão sendo utilizados para disseminar orientações sobre prevenção e cuidados necessários.
A prioridade das autoridades é garantir a segurança da comunidade local, além de evitar a propagação da doença. Monitoramentos contínuos estão em execução para proteger a população.
“Com informações de: Google Trends.”